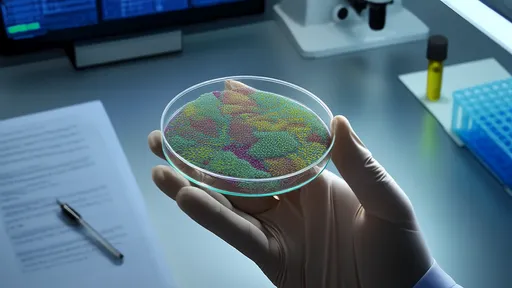

The concept of late-night museum hours isn’t new, but New York City has perfected it. Among the various cultural offerings that make the city pulse after dark, the Thursday extended hours at several major museums stand out as a unique blend of sophistication and accessibility. These extended openings provide an opportunity for both locals and visitors to experience world-class art, history, and science in a more intimate setting, away from the usual daytime crowds.
Bangkok’s night markets are legendary, offering everything from sizzling street food to quirky souvenirs. Among the most famous are Train Night Market Ratchada (Talad Rot Fai Ratchada) and Srinakarin Train Night Market (Talad Rot Fai Srinakarin). Both draw crowds of locals and tourists, but they cater to slightly different vibes and experiences. Deciding which one to visit depends on what you’re looking for—whether it’s convenience, variety, or a more nostalgic atmosphere.
As winter blankets Hokkaido in a pristine layer of snow, a unique adventure awaits those who seek both warmth and wonder. The iconic Stove Train, or "Dairo" as locals affectionately call it, chugs through the frosty landscapes, offering passengers a nostalgic ride back in time. Meanwhile, the serene Swan Lake (Kussharo-ko) transforms into a haven for graceful whooper swans migrating from Siberia. Together, they form an unforgettable day trip that captures the essence of Hokkaido's winter magic.
Venice, the floating city of canals, offers countless enchanting experiences, and a gondola ride is undoubtedly one of the most iconic. Yet, for many visitors, the dreamy excursion can quickly turn sour if they fall prey to tourist traps. Knowing how to identify authentic gondola stations and negotiate a fair price is essential to ensure a memorable—and not regrettable—experience.
The vermilion torii gates of Fushimi Inari Taisha wind like a ribbon through the forested mountainside, creating one of Kyoto's most iconic and photographed scenes. Yet for visitors hoping to capture the magic of these thousands of gates without hordes of tourists in their shots, timing and strategy become as important as camera settings.
The Grand Canyon stands as one of Earth's most awe-inspiring natural wonders, drawing millions of visitors each year who seek to experience its vast beauty. For travelers planning their adventure, the choice between exploring by helicopter or on foot presents two fundamentally different ways to engage with this geological masterpiece - each offering unique perspectives and requiring different levels of physical and financial commitment.
The Forbidden City stands as one of Beijing's most magnificent landmarks, drawing millions of visitors each year who come to marvel at its imperial grandeur. Yet few realize that beyond the well-trodden central axis lies a secret network of pathways that offer tranquil alternatives to the bustling main thoroughfares. These hidden routes not only provide respite from the crowds but reveal intimate architectural details and forgotten corners of the palace complex that most tourists never see.
The Eiffel Tower at night is one of the most photographed landmarks in the world, yet capturing its magic in a fresh and unique way remains a challenge for many photographers. While the classic shots from Trocadéro or Champ de Mars are undeniably beautiful, there’s something thrilling about discovering lesser-known vantage points that offer a new perspective on this iconic structure. Combined with the art of long exposure, these hidden gems can transform your nighttime shots into breathtaking works of art.
The ancient city square buzzed with anticipation as the first notes of a traditional folk song floated through the air. What happened next seemed to defy both physics and imagination - jets of water began rising from the previously dry plaza, dancing in perfect synchrony with the melody. This wasn't magic but an extraordinary fusion of cultural heritage and cutting-edge technology: the world's first sound-controlled fountain array activated entirely by folk music.
The gallery walls hummed with a peculiar energy as visitors stepped onto the pressure-sensitive platform, their every footfall triggering cascades of light that painted topographic wonders across the darkened space. This was "Cartography of Weight" - an immersive installation where human movement became the brushstroke for ephemeral landscapes.
As urban sprawl continues to swallow the night sky with artificial light, a quiet revolution is taking shape across the globe. Dark sky preserves—protected areas specifically designated to minimize light pollution—are emerging as sanctuaries where celestial wonders remain visible to the naked eye. These reserves are not merely nostalgic throwbacks to pre-industrial nights; they represent a deliberate cultural choice to preserve one of humanity’s oldest connections with the cosmos.
In an unassuming field outside Tucson, Arizona, a team of archaeologists is quietly conducting one of the most unconventional experiments in material culture studies. They're not digging for ancient relics - instead, they're burying contemporary objects to create what they call "future fossils." This radical approach to understanding human civilization through its discarded items could revolutionize how we document the Anthropocene epoch.
In the remote highlands of Norway, an ambitious project is quietly rewriting the rules of cultural preservation. The Arctic World Archive, a subterranean vault carved into a frozen mountainside, has become the unlikely guardian of humanity's cinematic heritage. Here, reels of film containing classic movies, documentaries, and newsreels sleep in the perpetual cold, protected against the ravages of time and potential global catastrophes.
The quiet hum of an elderly woman singing a lullaby in a vanishing dialect echoes through the recording studio. Her voice, weathered by time yet rich with cultural memory, is being preserved in a digital vault—part of an ambitious global initiative known as the Language Capsule Project. This endeavor, often referred to as the "Recording Cellar for Endangered Dialects," seeks to document and safeguard linguistic diversity before it disappears into the silence of history.
Pregnancy is a transformative journey that demands meticulous attention to nutritional needs. The concept of a dynamic nutritional demand spectrum during gestation has gained traction among researchers and healthcare providers alike. This approach recognizes that maternal requirements evolve dramatically across trimesters, influenced by fetal development stages and metabolic adaptations.
The human microbiome has emerged as one of the most fascinating frontiers in modern medical research. Comprising trillions of microorganisms inhabiting our bodies, these microbial communities play a pivotal role in health and disease. Microbial testing, which involves sequencing and analyzing these complex ecosystems, offers unprecedented insights into personalized medicine. However, interpreting microbiome data requires a nuanced understanding of both biological context and technological limitations.
The field of regenerative medicine has witnessed unprecedented breakthroughs in recent years, pushing the boundaries of what was once considered science fiction into tangible reality. Scientists and researchers across the globe are making strides in harnessing the body's innate ability to heal itself, offering hope for conditions previously deemed incurable. From stem cell therapies to tissue engineering, the advancements are not only redefining medical treatment but also challenging our understanding of human biology.
In the rapidly evolving landscape of modern healthcare, drug interaction alert systems have emerged as critical safeguards against potentially dangerous medication combinations. These sophisticated digital tools analyze prescription patterns in real-time, flagging possible adverse reactions before they reach patients. As polypharmacy becomes increasingly common—particularly among aging populations—the need for reliable interaction screening has never been greater.
The rapid advancement of genetic testing technologies has revolutionized modern medicine, offering unprecedented insights into human health and disease. However, as these tools become more accessible, the medical community faces growing challenges in defining their appropriate clinical applications. The boundary between what can be done and what should be done in genetic testing remains a subject of intense debate among researchers, clinicians, and ethicists.
The days leading up to surgery are often filled with anxiety about the procedure itself, but what many patients don't realize is that their nutritional status plays a pivotal role in determining outcomes. Surgical teams worldwide are increasingly recognizing that preoperative nutrition isn't just about fasting protocols - it's about strategically preparing the body for the metabolic stress of surgery. This paradigm shift has transformed how we approach the preoperative period, moving from simply clearing patients for surgery to actively optimizing their physiological resilience.
The process of wound healing is a complex and dynamic series of events that the body initiates in response to injury. Effective wound care requires an understanding of the distinct phases of healing, as each stage demands specific attention and intervention. From the moment a wound occurs, the body orchestrates a meticulous repair process, and healthcare providers must adapt their strategies to support optimal recovery. This article explores the nuanced approach to wound care across different healing stages, emphasizing practical clinical considerations.
Pain is an inevitable part of the human experience, yet the way we manage it doesn’t always have to involve reaching for a pill bottle. Non-pharmacological pain management strategies are gaining traction as both patients and healthcare providers seek alternatives that address discomfort without the potential side effects or dependencies associated with medications. These approaches often focus on holistic healing, empowering individuals to take an active role in their own well-being.
The realm of medical imaging has revolutionized modern healthcare, offering clinicians a window into the human body without the need for invasive procedures. Among the most critical aspects of utilizing these technologies effectively is understanding the precise indications for each imaging modality. The concept of indication-based imaging ensures that patients receive the most appropriate test, balancing diagnostic accuracy with safety and cost-efficiency. This approach minimizes unnecessary exposure to radiation, reduces healthcare expenditures, and streamlines patient care pathways.
The science behind vaccination has never been more visible than in our current era, where animated explanations have become crucial tools for public understanding. These dynamic visualizations peel back the layers of immunological complexity to reveal how vaccines train our bodies to recognize and combat pathogens. Through colorful simulations and simplified molecular interactions, animation bridges the gap between laboratory research and mainstream comprehension.
The rise of antibiotic resistance is one of the most pressing public health challenges of our time. As bacteria evolve to withstand the drugs designed to kill them, infections that were once easily treatable are becoming increasingly difficult to manage. Understanding the mechanisms behind antibiotic resistance is crucial for developing strategies to combat this growing threat. The complexity of resistance development involves genetic mutations, horizontal gene transfer, and the selective pressure exerted by antibiotic overuse.
In today’s world, where consumers are increasingly conscious of health and environmental impacts, the safety of clothing materials has become a critical consideration. The fabrics we wear daily come into direct contact with our skin, making it essential to understand how different materials affect our well-being. From synthetic fibers to natural textiles, each type carries its own set of advantages and potential risks. Navigating this landscape requires a deeper look into the origins, manufacturing processes, and long-term effects of these materials.
In an era where urbanization and industrialization dominate, the air we breathe has become increasingly polluted with harmful toxins and chemicals. While advanced air purification systems exist, nature offers a simpler, more sustainable solution: green plants. Beyond their aesthetic appeal, plants possess remarkable air-purifying abilities that can significantly improve indoor air quality. This natural approach to detoxifying our living spaces is not only cost-effective but also aligns with the growing global emphasis on eco-friendly solutions.
The relationship between temperature, humidity, and respiratory health has long been a subject of scientific inquiry. As climate patterns shift and urban environments become more controlled, understanding how these factors interact is crucial for public health. The human respiratory system is remarkably sensitive to changes in its immediate atmosphere, reacting in ways that can either protect or compromise our well-being.
In today's digital age, screens have become an inseparable part of our daily lives. Whether for work, entertainment, or communication, we spend countless hours staring at monitors, smartphones, and tablets. However, prolonged screen exposure can lead to digital eye strain, fatigue, and even long-term vision problems. Optimizing screen settings for visual health is no longer a luxury—it’s a necessity.
For millions of allergy sufferers, home should be a sanctuary—yet common household allergens often turn living spaces into sources of constant discomfort. The key to reclaiming your space lies in strategic modifications that minimize exposure to triggers like dust mites, pet dander, mold, and pollen. While complete elimination is impossible, targeted changes to your home’s design, cleaning routines, and airflow can dramatically improve quality of life.
The hum of traffic outside your window, the distant wail of sirens, or even the occasional barking dog – environmental noise is an inescapable part of modern urban living. While we often adapt to these sounds during waking hours, their impact on sleep quality remains a significant public health concern. Scientists have long studied the threshold at which ambient noise begins to disrupt our slumber, revealing complex interactions between sound characteristics, individual sensitivity, and physiological responses.
The ultraviolet (UV) index serves as a crucial tool for understanding the intensity of UV radiation in a given location at a particular time. Developed by scientists and health organizations, this numerical scale helps individuals assess their risk of UV exposure and take appropriate protective measures. As UV radiation can cause significant harm to the skin, eyes, and immune system, understanding how to interpret and respond to different UV index levels is essential for maintaining long-term health.
In today's fast-paced world, where many of us spend hours seated at desks or lounging on sofas, the importance of ergonomic furniture cannot be overstated. The right furniture can make the difference between a productive, pain-free day and one plagued by discomfort and fatigue. Understanding how to select pieces that align with the principles of ergonomics is essential for both short-term comfort and long-term health.
The quest for clean drinking water has driven innovation in filtration technologies, each promising to deliver purity through distinct scientific approaches. From activated carbon to reverse osmosis, the choices available to consumers and industries reflect a complex interplay of chemistry, physics, and engineering. Understanding these methods requires peeling back layers of technical jargon to reveal their real-world efficacy, limitations, and suitability for different water quality challenges.
 Travel
Travel
 Travel
Travel
 Travel
Travel
 Travel
Travel
 Travel
Travel
 Travel
Travel
 Travel
Travel
 Travel
Travel












 TOP
TOP
TOP
TOP
 TOP
TOP
 TOP
TOP
 TOP
TOP
 TOP
TOP
 TOP
TOP
 TOP
TOP
 TOP
TOP
 TOP
TOP
 TOP
TOP
 TOP
TOP
 TOP
TOP
 TOP
TOP
 TOP
TOP
 TOP
TOP
 TOP
TOP
 TOP
TOP
 TOP
TOP
 TOP
TOP